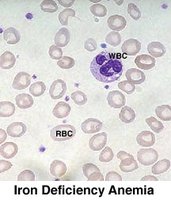
Blood smear showing iron deficiency anemia
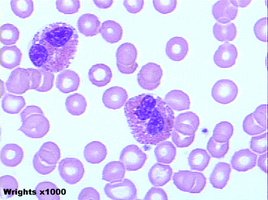
Blood smear showing eosinophilia
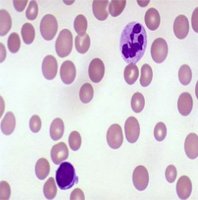
Blood smear showing hypersegmented neutrophil in pernicious anemia
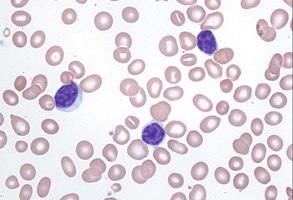
Blood smear showing increased lymphocytes in chronic lymphocytic leukemia

BackBIOL 204L Lab Practical I Review: Blood, Heart, Circulation, and Lymphatic System
Study Guide - Smart Notes
Tailored notes based on your materials, expanded with key definitions, examples, and context.
Lab 1: Blood
Blood Histology and Cell Types
Blood is a specialized connective tissue composed of plasma and formed elements, including erythrocytes, leukocytes, and platelets. Understanding the morphology and function of these cells is essential for recognizing normal and pathological states.
Erythrocytes (RBCs): Biconcave, anucleate cells responsible for oxygen transport via hemoglobin.
Leukocytes (WBCs): Nucleated cells involved in immune defense. Major types include neutrophils, lymphocytes, monocytes, eosinophils, and basophils.
Platelets: Small cell fragments crucial for blood clotting.
Mnemonic: "Never Let Monkeys Eat Bananas" helps recall the order of leukocytes by abundance: Neutrophils, Lymphocytes, Monocytes, Eosinophils, Basophils.


Blood Typing
Blood types are determined by the presence or absence of specific antigens (agglutinogens) on the surface of erythrocytes. The ABO and Rh systems are clinically significant for transfusions.
Type B-: Has B antigen; anti-A and anti-D antibodies present in plasma.
Transfusion Compatibility:
Can receive: B-, O-
Can donate to: B-, B+, AB-, AB+
Agglutinogens: Surface antigens (e.g., B antigen for type B blood).
Agglutinins: Plasma antibodies (e.g., anti-A, anti-D for B- blood).

Lab 2: Blood Pathologies
Common Blood Disorders
Microscopic examination of blood smears can reveal pathological changes in blood cell morphology and abundance.
Iron Deficiency Anemia: Characterized by microcytic (small), hypochromic (pale) RBCs due to insufficient hemoglobin synthesis.
Eosinophilia: Increased number of eosinophils, often associated with allergic reactions or parasitic infections.
Pernicious Anemia: Presence of hypersegmented neutrophils, caused by vitamin B12 deficiency.
Chronic Lymphocytic Leukemia: Marked by increased lymphocytes in peripheral blood.

Lab 2: Heart Anatomy and Blood Flow
Internal and External Heart Anatomy
The heart is a muscular organ divided into four chambers: two atria and two ventricles. Valves ensure unidirectional blood flow and prevent backflow.
Internal Structures: Superior vena cava, right atrium, tricuspid valve, right ventricle, pulmonary semilunar valve, pulmonary trunk, left atrium, bicuspid (mitral) valve, left ventricle, aortic semilunar valve, aorta, chordae tendineae, papillary muscles, apex.
External Structures: Coronary arteries and veins, auricles, and major vessels entering and leaving the heart.
Pectinate Muscles: Found in auricles; comb-like appearance.





Blood Flow Through the Heart
Blood flows through the heart in a specific sequence, ensuring oxygenation and systemic distribution.
Superior/Inferior vena cava → Right atrium
Tricuspid valve → Right ventricle
Pulmonary semilunar valve → Pulmonary trunk → Pulmonary arteries → Lungs
Pulmonary veins → Left atrium
Bicuspid (mitral) valve → Left ventricle
Aortic semilunar valve → Aorta → Systemic circulation
Lab 3: Circulation
Cerebral Circulation: The Circle of Willis
The brain receives blood through a specialized arterial circle at its base, known as the Circle of Willis. This structure provides collateral circulation to prevent ischemia.
Main arteries: Anterior communicating, posterior communicating, anterior cerebral, posterior cerebral, basilar, vertebral arteries.


Dural Venous Sinuses & Fetal Circulation
Dural venous sinuses drain blood from the brain, while fetal circulation includes unique structures for oxygen and nutrient exchange via the placenta.
Dural Sinuses: Superior sagittal, inferior sagittal, straight sinus.
Fetal Circulation: Umbilical vein, umbilical arteries, foramen ovale, ductus arteriosus (not shown), placenta.


Abdominal Blood Vessels
The abdominal aorta gives rise to major arteries supplying abdominal organs, while the hepatic portal system drains nutrient-rich blood from the digestive tract to the liver.
Key arteries: Celiac trunk, superior mesenteric, inferior mesenteric, renal, gonadal, common iliac arteries.
Key veins: Hepatic portal vein, hepatic vein, inferior vena cava.

Blood Vessels of the Upper and Lower Limbs
Major arteries and veins of the limbs are named according to their anatomical location and the regions they supply or drain.
Upper limb arteries: Subclavian, axillary, brachial, radial, ulnar, palmar arches.
Upper limb veins: Cephalic, basilic, median cubital, subclavian, jugular.
Lower limb arteries: Femoral, deep femoral, popliteal, anterior tibial, posterior tibial, dorsalis pedis.
Lower limb veins: Great saphenous, small saphenous, femoral, popliteal, tibial veins.







Lab 4: Lymphatic System
Lymphatic Organs and Drainage
The lymphatic system returns interstitial fluid to the bloodstream and provides immune surveillance. Major lymph nodes are located in the axillary, cervical, and inguinal regions. The spleen and MALT (mucosa-associated lymphoid tissue) are also key lymphatic organs.
Thoracic duct: Drains left head, neck, arm, thorax, and all regions below the diaphragm.
Right lymphatic duct: Drains right head, neck, arm, and thorax.
Cisterna chyli: Enlarged sac at the lower end of the thoracic duct.


Lymphatic Histology
Lymph nodes are encapsulated structures containing lymphoid follicles, germinal centers, and medullary cords. They filter lymph and house immune cells.
Cortex: Contains follicles with germinal centers.
Medulla: Contains medullary cords and sinuses.
Capsule: Dense connective tissue surrounding the node.

Lab 5: Cardiac Conduction and EKG
Intrinsic Conduction System
The heart's intrinsic conduction system coordinates contraction and ensures efficient pumping. Key components include:
Sinoatrial (SA) node: Pacemaker; initiates impulse.
Atrioventricular (AV) node: Delays impulse before passing to ventricles.
AV bundle (Bundle of His): Conducts impulse to bundle branches.
Bundle branches: Carry impulse through interventricular septum.
Purkinje fibers: Distribute impulse to ventricular myocardium.
Electrocardiogram (EKG/ECG)
An EKG records the electrical activity of the heart. Key waveforms include:
P wave: Atrial depolarization.
QRS complex: Ventricular depolarization (masks atrial repolarization).
T wave: Ventricular repolarization.
Heart Rate Calculation:
Normal heart rate: ~75 bpm; Tachycardia: >100 bpm; Bradycardia: <60 bpm.
Mean Arterial Pressure (MAP):
Blood Pressure: Systolic (max during contraction) / Diastolic (max during relaxation), measured in mmHg.
P wave duration: Number of small squares × 0.04 s (e.g., 2 squares × 0.04 s = 0.08 s).
Lab 6: Blood Pressure Measurement
Instruments
Sphygmomanometer: Measures systolic and diastolic blood pressure.
Pulse plethysmograph: Records changes in pulse.
Stethoscope: Used to listen to the Sounds of Korotkoff during blood pressure measurement.